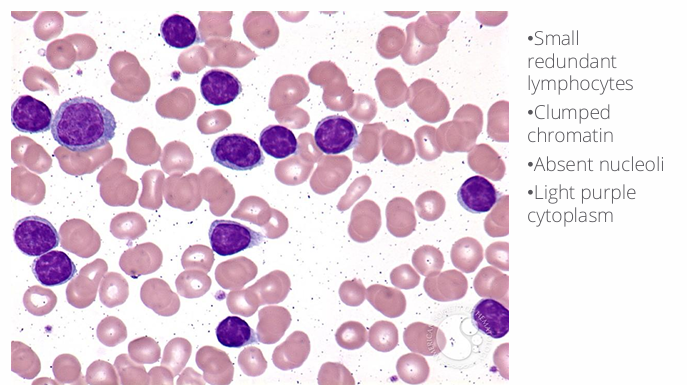
knowt flashcard image
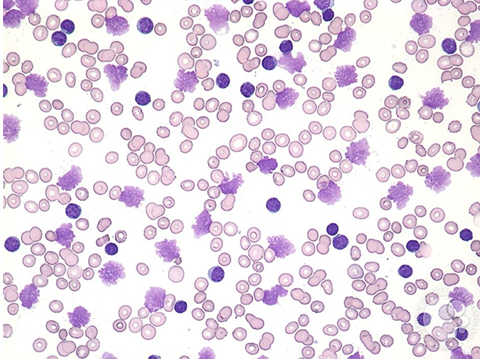
term image

1/49
Looks like no tags are added yet.
Name | Mastery | Learn | Test | Matching | Spaced |
|---|
No study sessions yet.
lymphocytic leukemias

lymphocytic leukemias- cell of origin

key differences between ALL and CLL

ALL

ALL patient presentation

ALL lymphoblasts microscopic appearance

ALL physical exam

T-cell ALL- mediastinal mass

ALL diagnosis

ALL lymphocyte development

ALL diagnosis- flow cytometry

adverse prognostic factors

ALL- chromosomal prognostics via FISH

ALL stages of therapy

ALL therapy- chemotherapeutics

complications of ALL therapy- tumor lysis syndrome
-management: hydration, allopurinol, rasburicase

measurable (minimal) residual disease (MRD)

presence of MRD

improved survival in pediatric ALL by
-year of diagnosis
survival difference in AYA ALL

ALL- allogeneic transplant

ALL- blinatumomab to eliminate MRD

CD19 CAR T cells in ALL

ALL high yield recap

CLL

CLL- memory B cell “cell of origin”

CLL peripheral smear

-CLL- smudge cells
-”crushed little lymphocytes”
CLL cells 3 compartments of development

CLL patient presentation

CLL diagnosis

CLL staging

prognostic factors

iFISH- recurrent copy number alterations (CNA) in CLL

risk stratification by CNA- prognosis

CLL “cell of origin”
-IGHV mutation

heavy chain hypervariable region (IGHV) mutation and prognosis

prognostic factors- IGHV mutational status

CLL immune dysregulation

CLL mechanisms of thrombocytopenia

CLL indications for treatment

evolution of CLL therapy

array of novel agents active in CLL

modern goals of therapy for patients with CLL

BTKi v. Ven-G in TN CLL- clinical considerations

ibrutinib

toxicities of ibrutinib

venetoclax

CLL take home points

summary
